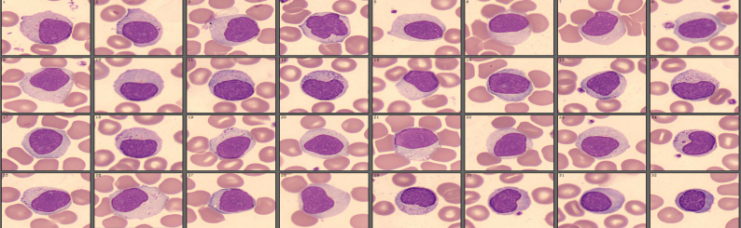
3
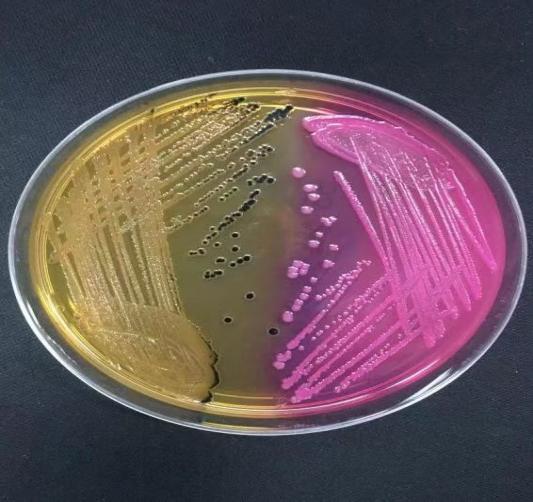
973d8388502be2645d05e7b7a55e1b4
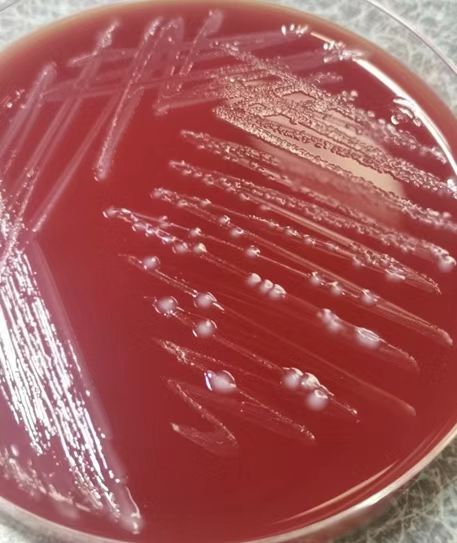
5ffce8223b22ac34a6806a8e8d87069

科室概况
四川大学华西医院锦城医院实验医学科,是在四川大学华西医院实验医学科的指导下,按照同质化及一体化管理原则建设的高标准医学检验诊断中心。科室现有临床生化免疫组、临检血液组、临床体液组、临床微生物组、临床分子组五个亚组。科室秉持着华西医院实验医学科“精湛的技术、准确的结果、优质的服务”的服务宗旨,配备一流的技术团队、先进的检测仪器和国际认可的质量标准,提供精准的医学检验技术,服务于患者,贡献于社会。
团队图片

亚专业组
科室配备多位经验丰富的检验专家和国际先进的分析仪设备,以高素质的专业技术队伍、优化的工作流程,开展涵盖生化、激素、血细胞分析、肿瘤标志物、大小便常规、病原体检测等数百项检验项目,为疾病的诊断、鉴别诊断、治疗监测、预后评估提供有力的实验室证据。
临床生化免疫组
配备全自动样品前、后处理系统、全自动生化分析仪、电化学发光分析仪等,可完成肝功能、肾功能、血糖、血脂系列、酶学系列、激素类、心肌标志物、肿瘤标志物、乙肝两对半、丙肝抗体等200余项检测项目。
临检血液组
拥有多名具有血液形态学丰富经验的老师,采用国际先进的血细胞分析流水线,配备自动阅片仪、血沉仪等,常规开展血细胞分析、网织红细胞计数、止凝血项目、血沉及人工白细胞分类计数等检查,提供准确的结果报告。

临床体液项目:
常规开展小便干化学及沉渣分析、大便常规及隐血、各种体液常规及其他特色项目检查。
临床微生物组:
科室现有血培养仪、结核分析仪、细菌鉴定及药敏分析仪、质谱鉴定仪等仪器,可开展各类标本的细菌、真菌培养鉴定及药敏实验,结核 γ干扰素释放实验,G实验等,为查找病原体提供有力依据。

临床分子组
科室现有核酸提取仪、PCR仪、基因分析仪等先进设备,可对多种病原体等进行核酸检测,实现快速准确的诊断。
专家团队
周易
副主任技师,博士,四川省妇幼保健协会分子诊断及代谢组学专业委员会委员,四川省结核病防治综合质量控制专家指导委员会委员,长期从事临床医学检验工作,主持与参与多项国自然或省科技厅项目,发表SCI论文10余篇。
罗通行
副主任技师,中国医药生物技术协会生物安全协会委员,中国分析测试协会委员。主持与参与省科技厅课题3项,参与课题获四川省科技进步三等奖1项,参加教材及专著编写7部,承担临床生化项目结果的自动审核与临床应用研究,将自动审核技术应用于实验室临床生化报告审核。
卢兴兵
主管技师/临床检验诊断学医师。工作至今主要从事临床病原微生物学诊断。2018年首批加入国际应急救援队EMT第一梯队,参与省部级课题3项,参编人卫版《检验与临床的沟通》等专著4部,实用型专利2项。发表文章20余篇,其中SCI 8篇。
张天聪
四川大学华西医院/四川省公共卫生临床综合中心技师,研究生学历,硕士学位,专业方向:临床血液检验。在血细胞分类、形态学检测有较强的专业能力,审核报告万余份,以第一作者/共同第一作者发表SCI论文5篇,参与多项省部级及横向课题研究工作。
翟建昭
四川大学华西医院/四川省公共卫生临床综合中心技师,研究生学历,硕士学位,专业方向:感染性疾病的分子诊断。2022年毕业于四川大学华西临床医学院获硕士学位,毕业后于四川大学华西医院实验医学科工作迄今,长期从事感染性疾病分子诊断和遗传基因检测工作。
王新宇
四川大学华西医院/四川省公共卫生临床综合中心技师。专业方向:临床生化检验。2021年毕业于西南医科大学获学士学位,毕业后于四川大学华西医院实验医学科工作迄今,长期从事生化、激素报告审核工作。
缪诗琪
四川大学华西医院锦城医院/四川省公共卫生临床综合中心技师,研究生学历,硕士学位。2022年毕业于重庆医科大学获硕士学位,主要从事临检检测相关工作,以第一作者发表SCI论文1篇。
杨丰源
四川大学华西医院锦城医院/四川省公共卫生临床综合中心技师,研究生学历,硕士学位。2024年毕业于温州医科大学获硕士学位,主要从事生化检测相关工作,以第一作者发表SCI论文1篇。